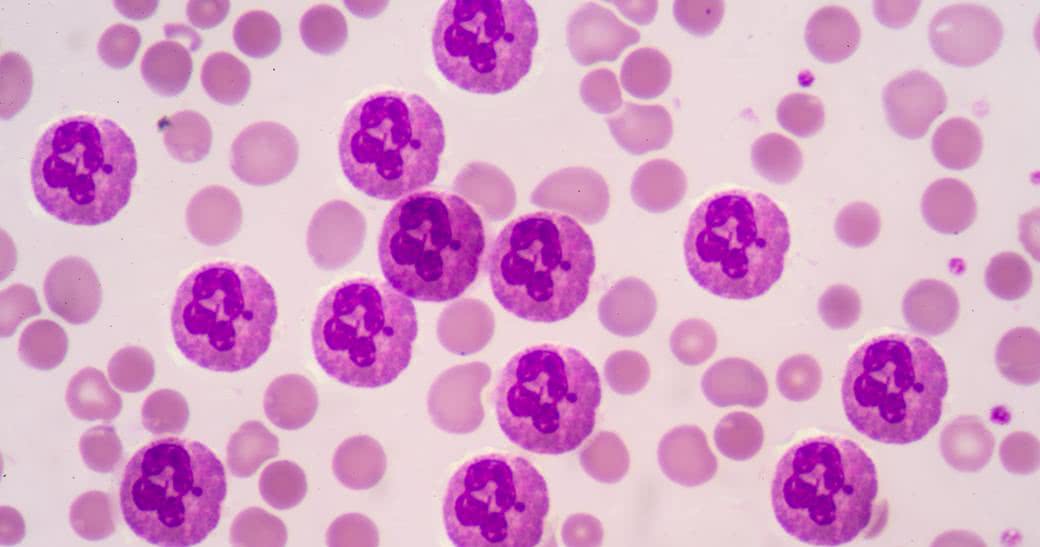

Złocień maruna - pospolita roślina ogrodowa, która zwalcza migrenę i ból stawów, a także pomaga w leczeniu białaczki, powszechnie uważanej za przewlekłą i wręcz nieuleczalną chorobę. Naukowcy wyizolowali ze złocienia maruna związek o nazwie partenolid, który ma zadanie zabijać komórki przewlekłej białaczki limfocytowej (CLL).
Naukowcy z University of Birmingham w Wielkiej Brytanii odkryli metodę izolowania i modyfikacji tego związku w celu zwiększenia jego właściwości przeciwnowotworowych. Partenolid zwiększa liczbę niestabilnych cząsteczek w komórkach rakowych, dopóki nie osiągną punktu, w którym ulegną samozniszczeniu.
Badania pokazują, że niewiele jest związków, które w taki sposób, jak pertenolid atakują komórki CLL. Podobne wnioski zgłaszali już w 2005 r. naukowcy z University of Rochester Medical School, którzy odkryli, że 18 godzinna ekspozycja na partenolid może zabić komórki białaczkowe, pozostawiając wokół nich same zdrowe komórki.
Naukowcy z Rochester odkryli również, że partenolid jest skuteczniejszy niż cytarabina - standardowy lek przeciw białaczce, ponieważ jest ona "umiarkowanie toksyczna" dla komórek rakowych, ale "wysoce toksyczna" dla zdrowych komórek, a więc może wyrządzić więcej szkody niż pożytku.
Źródło: MedChemComm, 2019; 10: 1379-90

 Nasze magazyny
Nasze magazyny